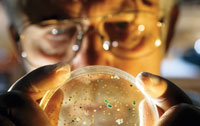
petri dish

Tromsø in Norway is a long way from pretty much everywhere. However, its northerly position, 300 km inside the Arctic Circle, was a perfect location for hosting BIOPROSP, an international biennial conference on bioprospecting – the search for new biologically active compounds from cold marine environments, including the Arctic and Antarctic.
To survive the extreme temperatures, pressures and salinity levels in the polar regions, organisms – from bacteria, fungi, archaea and algae to crustaceans and fish – have had to adapt. One way of doing this is by producing unique proteins, peptides and metabolites, which differ from those produced by organisms found in more temperate terrestrial regions and could have potential in the biopharma, biotechnology and food industries.
Speaking at BIOPROSP, Paul Wender of Stanford University, US, explained: ‘3.8bn years of evolution have produced a very rich library of natural products, and scientists have really only started exploring and understanding these in the last 50 years.’
Exploiting natural products
The pharma and biotech industries have traditionally been wary of natural products, seeing them as complex, unstable, difficult to isolate and characterise, and having variable potency. Wender suggested that the solution to exploiting these compounds comes down to informed design. Different companies are adopting different strategies to do this.
Aquapharm has cultured 9000 microbial and fungal strains sourced from shallow brackish water in the depths of the Arctic Ocean. From this library, the company created a microbial database, which includes information on the source of the bacteria (including location), the culture conditions, and the bacterial activity. This library is screened to find bacteria showing specific biological activity; these are then cultured and the natural products isolated for further development.
By this process, the company develops new therapeutics for the pharmaceutical, consumer health and personal care industry, including potential anti-infective, anti-inflammatory and antioxidant agents, as well as enzymes for biocatalysis in industrial biotechnology. Aquapharm has recently signed a deal with Indian pharma major Dr Reddy's to screen the microbial database for novel biocatalysts.
Academic interest
As well as attracting commercial interest, these microorganisms are being studied by a number of university research groups. Alan T. Bull and his colleagues in the school of biosciences at the University of Kent, UK, study actinobacteria that live in extreme environments, including the Arctic. Actinobacteria produce around 45% of all microbial bioactive chemicals and are ‘arguably the richest source of small molecule diversity on the planet’.1
Bull’s research group isolated the actinobacterium Verrucosispora in Raune Fjord, Norway, at depths of 250m, and is working on sequencing the complete genome. A strain of Verrucosispora, MG-37, produced three novel aminofuran antibiotics – Proximicin A, B and C, which showed only weak antibacterial activity, but strong anticancer properties and induced cell death.2 They did not make it into the clinic but show the potential of Arctic bacteria.
Bull admitted that there are issues in developing natural products, and they are still learning lessons – for example, the missing steps between hit and lead, and not having enough contacts in pharmaceutical companies to gain support and interest. He also highlighted strategies for accessing undiscovered natural products, such as focusing on novel organisms like actinobacteria; focusing on the genes to maximise gene expression; and carrying out whole genome sequencing to screen for biosynthetic gene clusters. ‘It’s also important to look beyond the genome to metagenomics, and look at DNA taken from bacteria isolated from the environment rather than those cloned in the laboratory,’ he said.
Elucidating the pathways that bacteria use to make natural products provides valuable information on how to manipulate organisms genetically to improve yields, or produce new and potentially useful molecules. Trygve Brautaset and his colleagues at SINTEF, an independent research organisation in Scandinavia, are using this approach to produce carotenoids from Arctic bacteria. Some carotenoids provide UV protection and have antioxidant activity. The isolation of new sources of known, as well as novel, carotenoids is therefore of potential interest not only to the biopharma industry for new therapeutics, but also to the food and cosmetic industries as antioxidants, colours and UV filters.
Brautaset’s team characterised 300 bacteria from the sea surface microlayer of a Trondheim fjord and selected the Micrococcus luteus strain Otnes7. These bacteria produce the bright yellow carotenoid, sarcinaxanthin, which absorbs in the UVA blue range.
The team cloned the carotenoid genes and expressed the biosynthetic gene cluster (crtE, crtB, crtI, crtE2, crtYg, crtYh, and crtX) in E. coli, but this only produced sarcinaxanthin at very low levels. By shifting to a lycopene-producing strain of E. coli and adding different genes, the team was able to identify the intermediates and pathways.3 The researchers then created a hybrid gene cluster from the sarcinaxanthin producer M. luteus and the decaprenoxanthin Corynebacterium glutamicum, which produced decaprenoxanthin and sarcinaxanthin as expected, as well as a third and new carotenoid, sarprenoxanthin, which will be investigated for its antioxidant activity.
Plankton and sustainability
Not all sources for marine bioprospecting are bacterial. Terje Larsen at the University of Tromsø reported on the marine copepod Calanus finmarchicus as a potential food supplement. This planktonic crustacean is common in the North Atlantic, from the Arctic down to Chesapeake Bay, at depths of around 200m.
Larsen and his team studied the oil extracted from the organism for Calanus, a Norwegian biomarine company created to exploit its potential. The oil is high in the omega-3-fatty acids EPA (eicosapentaenoic acid), DHA (docosahexaenoic acid) and SDA (stearidonic acid), as well as astaxanthin, a carotenoid, and may have potential in reducing obesity and insulin resistance, which can lead to Type II diabetes.
In an experiment, mice fed on a high-fat diet dosed with calanus oil showed a reduction in abdominal fat, improved glucose tolerance and reduced insulin resistance, as well as improved oxygen capacity, compared with mice not receiving the oil. The mice receiving the combination of calanus oil and a high-fat diet also showed reduced levels of hepatic steatorrhea (fatty liver), which can be associated with metabolic syndrome, including diabetes and obesity. In March 2011, Calanus began a double-blinded, randomised and placebo-controlled clinical trial in Norway, looking at the effect of calanus oil on abdominal fat, glucose tolerance and lipids in 120 healthy, moderately obese volunteers.
Industrial enzymes
Enzymes that have evolved for psychrophillic – coldadapted – bacteria are also attracting commercial interest. Such enzymes have the advantage of high activity, low-temperature optima, inactivation at high temperatures, and decreased substrate specificity. Adele Williamson from New Zealand, but currently based at the University of Tromsø, and her colleagues have taken bacterial samples from Lofoten Fjord and Barents Sea and sequenced the genomes. The team used the MetaGeneMark gene finding program to identify potential gene sequences for nitrilases and the National Center for Biotechnology Information (NCBI) BLAST database to find regions of similarity between biological sequences in different organisms to support these findings. The cold-adapted nitrilases arising from this research could have potential in industrial processes. In nature, nitrilases are part of natural product synthesis and post-translational modification in plants, animals, fungi and certain prokaryotes,4 and have been used as catalysts in preparative organic chemistry, including the synthesis of carboxylic acid derivatives.

According to Peter Stougaard of the University of Copenhagen, Denmark, the Ikaite tufa columns in the Ikka Fjord in southwest Greenland – with temperatures of 2–6 °C, salinity of 9–12% and a pH of 10.4 – are the ideal environment in which to find industrial enzymes. Proteases, amylases, cellulases and lipases, for example, would find use in laundry products. Of the 672 bacterial isolates analysed by Stougaard’s group, around one third are new species and genera, and most of the enzymes have little similarity to known enzymes, making this location and environment a major new resource for industry. The future of this exciting resource looks set to grow as more natural products move from the ocean to the bench.
Susanne Elvidge is a freelance writer based in Buxton, UK.
References
1. Miao, V. and Davies, J. Actinobacteria: the good, the bad, and the ugly., Antonie Van Leeuwenhoek, 2010, 98, 43.
2. Fiedler, H. P. et al., J Antibiot (Tokyo), 2008, 61, 158.
3. Netzer, R., et al., J. Bacteriol., 2010, 192, 5688.
4. Pace, H. C. and Brenner, C., Genome Biol., 2001, 2 (1).





